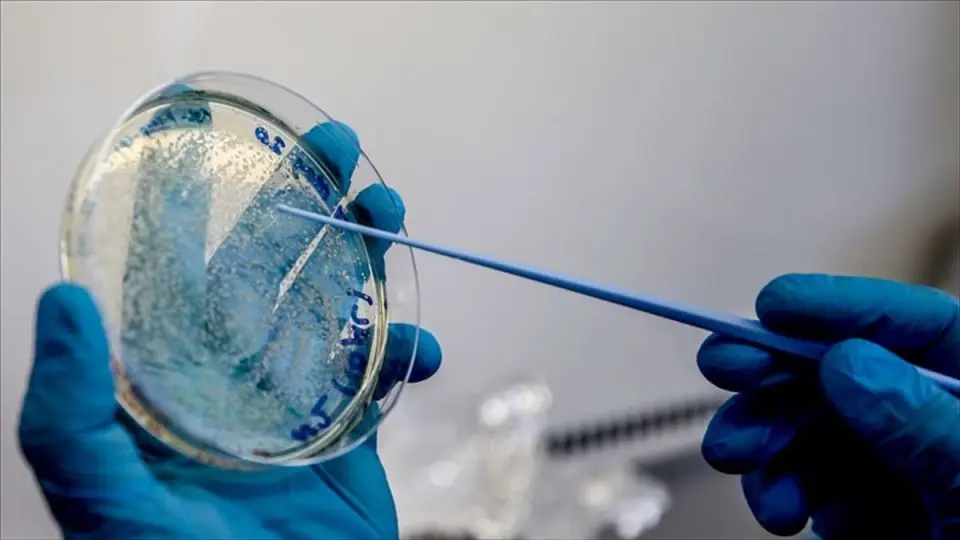

Almanya, Kovid-19 aşı geliştiricisi CureVac'ın yüzde 23 hissesini satın alıyor
BERLİN (AA) - Almanya Ekonomi ve Enerji Bakanı Peter Altmaier, Alman hükümetinin yeni tip koronavirüs (Kovid-19) tedavisine yönelik aşı ve biyomedikal ilaç üretme...
BERLİN (AA) - Almanya Ekonomi ve Enerji Bakanı Peter Altmaier, Alman hükümetinin yeni tip koronavirüs (Kovid-19) tedavisine yönelik aşı ve biyomedikal ilaç üretmek için çalışan biyoteknoloji şirketi CureVac'in yüzde 23 hissesini 300 milyon avroya satın alacağını bildirdi.
Altmaier, CureVac'ın en büyük hissedarı SAP kurucu ortağı Dietmar Hopp ile çevrim içi yaptığı toplantıda, Alman hükümetinin borsada işlem görmeyen CureVac'ın sermaye artırımını destekleyeceğini ifade etti.
Altmaier, şirketin yaklaşık yüzde 23 hissesinin Alman Kamu Yatırım Bankası (KfW) tarafından 300 milyon avro karşılığında satın alınması için Hopp ile anlaşmaya varıldığını duyurdu.
Alman hükümetinin Almanya'da biyoteknoloji sektörünü güçlendirmek istediğini ifade eden Altmaier, hükümetin Curevac'ın şirket politikası kararlarına müdahalede bulunmayacağını söyledi.
Altmaier, "Alman hükümeti, gelecek vadeden bu şirkete yatırım yapmaya karar verdi. Çünkü yatırımın şirketin geliştirme programlarına ivme katmasını ve CureVac'ın teknolojisinin tüm potansiyelini kullanması için araçlar sağlamasını bekliyor." diye konuştu.
Mart ayında, ABD Başkanı Donald Trump'ın, merkezi Almanya'da bulunan CureVac'ın Kovid-19'a karşı aşı çalışmalarını ABD'ye çekmek için büyük miktarda para teklif ettiği öne sürülmüştü.
CureVac, mRNA tabanlı bir koronavirüs aşısı geliştirilmesine odaklanıyor. Şirketin, ABD'nin Boston kentinde laboratuvarı da bulunuyor.